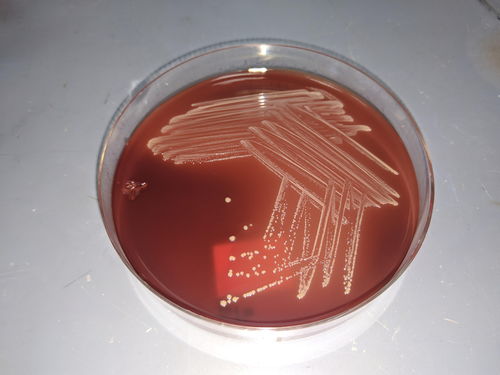
男子4.5米高坠后感染超级细菌：高烧不退脑脊液浑浊像果冻

男子4.5米高坠后感染超级细菌 高烧不退竟致脑脊液浑浊如果冻
当“超级细菌”鲍曼不动杆菌遇上高空坠落的严重创伤,人体的防御系统将面临怎样的考验?2024年4月,一则特殊病例揭开了这一残酷现实:一名男子从4.5米高处坠落,脾脏破裂、颅内出血、全身骨折等多重创伤接踵而至,而术后感染的“隐形杀手”——碳青霉烯耐药鲍曼不动杆菌(CRAB),让这场本就凶险的救治之路变得更加艰难。
高空坠落:身体防线的“双重冲击”
从4.5米高度坠落,对人体而言已是“致命冲击”,严重的机械性损伤直接导致脾脏破裂(需紧急切除以避免大出血)、颅内出血(可能引发脑水肿与脑压升高)、全身多处骨折(削弱骨骼与肌肉的物理屏障),术后转入重症监护室(ICU)时,患者不仅身体机能严重受损,免疫力也因创伤与手术降至冰点——这为细菌入侵创造了“绝佳环境”。
关键节点:术后第5天,持续高热(最高39.5℃)成为首个危险信号,退烧药与冰毯物理降温均无效,提示感染已突破基础防线,而后续检查更证实:细菌已悄然侵入中枢神经系统。
“胶冻样”脑脊液:超级细菌的“终极战场”
痰培养结果显示,致病菌为碳青霉烯耐药鲍曼不动杆菌(CRAB)——这是一种以“不动”著称的超级细菌,它无需依赖宿主能量,仅靠分解环境有机物即可存活,在干燥表面可滞留20天以上,且对多数抗生素(尤其是碳青霉烯类)具有天然耐药性,当CRAB通过血液扩散至脑部,脑脊液成为它的“温床”。
脑脊液的异常指标:
- 白细胞:29600×10⁶/L(正常0-8×10⁶/L,超标3700倍)
- 蛋白:>12000mg/L(正常0.15-0.45mg/L,超标超2.6万倍)
- 糖:0.43mmol/L(正常2.5-4.5mmol/L,几乎耗尽)
临床表现:脑脊液浑浊如“凝固的胶冻”,抽取2ml即迅速凝固,远超正常脑脊液的清亮状态,这意味着CRAB已在颅内形成“细菌池”,对神经组织造成不可逆损伤。
90天“持久战”:从ICU到康复的艰难突围
面对CRAB的“疯狂进攻”,华山医院神经外科与感染科团队展开联合攻坚:
- 第一步:精准给药,通过腰穿将抗生素直接注入脑脊液,同时调整方案,多黏菌素B、美罗培南、舒巴坦等药物“轮番上阵”,但CRAB的多重耐药性让初期治疗陷入僵局。
- 第二步:29天“日夜监测”,团队每6小时分析病情,动态调整抗生素浓度与剂量,同时通过CT、MRI等实时追踪颅内感染范围,最终在第29天成功控制感染扩散。
- 第三步:61天“康复重建”,感染控制后,需逐步修复受损神经功能、恢复体力,患者最终在ICU外接受61天后续治疗后康复出院。
全球耐药警报:我们如何应对“不动的威胁”?
CRAB的威胁远不止案例中的个体悲剧,据WHO 2024年数据,CRAB已成为全球第二大致死性耐药菌,每年造成超70万例院内感染,亚洲地区感染率较十年前上升42%(《柳叶刀》2023年研究),其耐药机制包括:
- 外排泵系统:主动“排出”抗生素,降低药物浓度;
- 生物膜形成:在植入物(如导管)表面形成“保护罩”,抗生素难以渗透;
- 基因突变:快速变异以规避药物作用靶点。
应对策略:
- 医院层面:严格执行手卫生、环境消毒(如紫外线+过氧化氢联合消毒)、抗生素使用监测;
- 公众层面:避免滥用抗生素(感冒、轻微感染不自行服药),接触公共设施后及时洗手;
- 研发层面:新型抗生素(如多粘菌素B脂质体)与噬菌体疗法逐步应用,需加速耐药菌监测与预警系统建设。
更多一手游戏信息请关注攻略蜂巢
迪士尼收购Epic Games传闻,时机成熟,玩家将迎来哪些游戏新变化?
英伟达PC应用程序测试版更新,后台自动重编译着色器省却手动等待
苏丹的游戏一周年,升华之战版本,80万字新故事线与后日谈实装